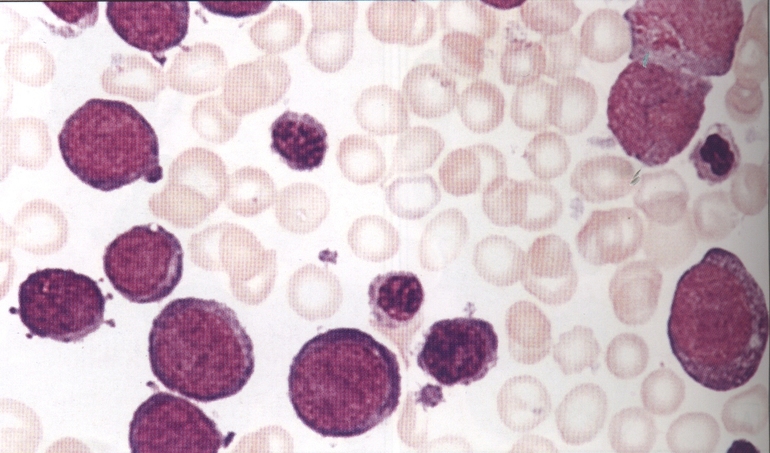
Прародителем эозинофилов выступает миелоидная клетка,
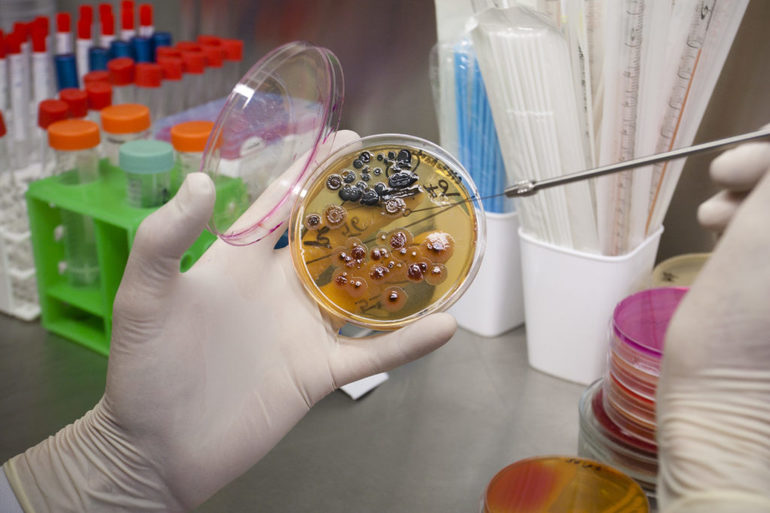
Назначают бакпосев.

Эозинофилы — это вид белых кровяных клеток, играющих ключевую роль в иммунной системе, особенно в борьбе с аллергиями и паразитарными инфекциями. Пониженный уровень эозинофилов, или эозинопения, может указывать на различные нарушения и требует анализа. В статье рассмотрим причины снижения уровня эозинофилов у взрослых и детей, а также методы диагностики и лечения. Понимание этих аспектов поможет читателям лучше ориентироваться в вопросах здоровья и реагировать на отклонения.
Лейкоцитарная формула крови
Лейкоциты различаются по своей структуре, качественным и количественным характеристикам, и при анализе крови служат индикаторами различных заболеваний в организме человека. Классификация лейкоцитов:
- лимфоциты;
- эозинофилы;
- моноциты;
- нейтрофилы;
- базофилы.
Лимфоциты отвечают за выработку антител против вирусных инфекций и участвуют в процессе фагоцитоза, то есть поглощают патогенные микроорганизмы и раковые клетки. Моноциты также обладают фагоцитарными свойствами, естественным образом захватывая чуждые организму элементы. Нейтрофилы производят вещества, способные уничтожать болезнетворные бактерии. Базофилы играют роль в транспортировке других лейкоцитов к местам воспаления и участвуют в нейтрализации аллергенов.
В норме соотношение всех типов лейкоцитов должно оставаться стабильным. Данные о белых кровяных клетках, полученные в ходе клинического анализа крови, называются лейкоцитарной формулой или лейкограммой. Этот анализ показывает процентное соотношение различных видов лейкоцитов и помогает выявить наличие или отсутствие воспалительных процессов в организме. Хотя по лейкограмме нельзя установить окончательный диагноз, она позволяет определить стадию и интенсивность заболевания, а также оценить эффективность назначенного лечения.

Снижение уровня эозинофилов в крови может быть связано с различными факторами, о чем отмечают врачи. Одной из основных причин является стресс, который может вызывать подавление иммунной системы. Также низкий уровень эозинофилов часто наблюдается при инфекционных заболеваниях, когда организм активно борется с патогенами, и ресурсы клеток перераспределяются. Врачи подчеркивают, что некоторые медикаменты, такие как кортикостероиды, могут приводить к снижению числа этих клеток. Кроме того, нарушения в работе щитовидной железы и аллергические реакции также могут влиять на уровень эозинофилов. Важно отметить, что для точной диагностики и определения причин необходимо комплексное обследование пациента.
Общая информация
Новые компоненты лейкоцитарной формулы были выявлены немецким ученым Паулем Эрлихом в процессе окрашивания мазка крови различными красителями. Препарат, названный в честь греческой богини утренней зари Эос — эозин, окрашивал 1−4% лейкоцитов в розоватый оттенок. В ходе исследований выяснилось, что это не предшественники эритроцитов, а отдельные клетки крови — эозинофилы. Интенсивное изучение этих клеток проводилось в 80-х годах XX века, что позволило установить их важнейшую роль в иммунной системе.
Эозинофилы происходят от миелоидных клеток, а их образование и созревание происходит в костном мозге под воздействием веществ, вырабатываемых Т-лимфоцитами и макрофагами. После завершения процесса созревания и попадания в кровоток, эти клетки больше не делятся, и их количество в крови составляет примерно 120−350 единиц на 1 мкл. Срок жизни эозинофилов невелик — около 12 дней, из которых только 6−12 часов они находятся в кровотоке, после чего проникают в ткани, где их концентрация примерно в 100 раз превышает количество в крови. Наибольшее скопление этих клеток наблюдается в следующих областях:
- легкие;
- кожные покровы;
- пространство под слизистой оболочкой желудочно-кишечного тракта.
Стресс и его влияние на систему кровиСтресс — это особая реакция человеческого организма, возникающая под воздействием различных факторов. В качестве…
После выполнения своей функции или в отсутствие раздражающих факторов, эозинофилы погибают. Увеличение их количества в крови выше нормы называется эозинофилией, а снижение — эозинопенией, однако такие изменения не всегда связаны с заболеваниями. Колебания могут происходить по естественным причинам, например, в ночное время суток количество этих клеток в кровотоке возрастает.
Частые стрессы, при которых вырабатывается гормон кортизол, могут приводить к снижению уровня эозинофилов в крови.
| Причина понижения эозинофилов | Механизм действия | Дополнительные комментарии |
|---|---|---|
| Острые инфекции (бактериальные, вирусные) | Выброс кортикостероидов надпочечниками в ответ на стресс, что подавляет продукцию и высвобождение эозинофилов из костного мозга. | Чаще всего наблюдается при тяжелых инфекциях, сепсисе. |
| Стресс (физический, эмоциональный) | Активация гипоталамо-гипофизарно-надпочечниковой оси, приводящая к повышению уровня кортизола. | Может быть вызван травмами, операциями, сильными эмоциональными переживаниями. |
| Прием кортикостероидов (системных или ингаляционных) | Прямое подавление образования и высвобождения эозинофилов из костного мозга, а также их миграции в ткани. | Дозозависимый эффект. Является ожидаемым побочным эффектом терапии. |
| Синдром Кушинга | Хронически повышенный уровень кортизола в организме. | Эндогенное повышение кортизола, приводящее к аналогичным эффектам, как и экзогенный прием. |
| Эклампсия | Тяжелое осложнение беременности, сопровождающееся высоким уровнем стресса и воспаления. | Сопровождается выраженным стрессовым ответом организма. |
| Шок (анафилактический, травматический, септический) | Массивная стрессовая реакция организма с выбросом большого количества кортикостероидов. | Критическое состояние, требующее немедленной медицинской помощи. |
| Ожоги | Обширное повреждение тканей вызывает сильный стрессовый ответ и воспаление. | Степень понижения эозинофилов коррелирует с тяжестью ожогов. |
| Острый аппендицит | Острое воспаление, сопровождающееся стрессовой реакцией. | Может быть одним из лабораторных признаков острого воспаления. |
| Некоторые злокачественные новообразования (редко) | Механизм не всегда полностью ясен, может быть связан с системным воспалением или выработкой опухолью определенных веществ. | Встречается реже, чем при других причинах. |
Строение эозинофилов
Почти вся цитоплазма эозинофильных лейкоцитов заполнена уникальными гранулами, что позволяет отнести их к группе гранулоцитов. В центре этих клеток располагается кристаллоид, содержащий так называемый основной белок, который включает в себя:
- аргинин;
- лизосомные ферменты;
- пероксидазу;
- катионный белок;
- гистаминазу.
Эозинофильные гранулоциты встречаются в периферической крови в небольшом количестве. Для взрослого человека нормальным считается уровень этих клеток в диапазоне 1−5% от общего числа лейкоцитов. У детей этот показатель может быть немного выше или изменяться, что связано с процессом формирования иммунной системы.
К моменту достижения пубертатного периода устанавливается уровень, характерный для взрослых. Именно поэтому в подростковом возрасте могут наблюдаться аллергические реакции, которые беспокоили детский организм.

Основные функции
Движение кровяных клеток известно как хемотаксис и может происходить под воздействием различных иммунных комплексов, лимфокинов, а также продуктов жизнедеятельности паразитов и злокачественных клеток. Кроме того, хемотаксис может инициироваться веществами, которые образуются в процессе аллергических реакций. Одним из самых мощных стимуляторов миграции эозинофилов в ткани является анафилактический фактор, который возникает под влиянием белков, вырабатываемых тучными клетками и базофилами, в частности, гистамина. Основные функции эозинофилов:
- Борьба с паразитами.
- Микрофагоцитоз.
- Регуляция аллергических реакций.
Эти кровяные клетки способны поглощать мелкие частицы патогенных микроорганизмов и их метаболитов, однако фагоцитоз у них выражен не так сильно. Главная специфическая задача эозинофильных лейкоцитов — борьба с паразитами. При заражениях гельминтами, шистосомами и другими паразитами количество эозинофилов значительно возрастает. Хемотаксические факторы привлекают их к очагам инфекции, где они обвивают паразитов с помощью компонентов комплемента, образующего защитную оболочку.
При этом эозинофилы подвергаются саморазрушению — происходит дегрануляция, в ходе которой выделяются основной белок и липидные медиаторы, способствующие разрушению клеток паразитов. Секреция гранул начинается очень быстро и может продолжаться несколько часов. Эти клетки особенно активны в местах внедрения паразитов, но менее эффективны в областях их окончательной локализации. Мелкие возбудители, такие как трематоды, могут быть полностью поглощены.
В случае аллергических реакций факторами хемотаксиса выступают гистамин и иммунные комплексы, состоящие из антигенов и антител. Эозинофилы препятствуют развитию аллергических и анафилактических реакций различными способами. Гистаминаза разрушает гистамин и лейкотриены. Дегрануляция базофилов и тучных клеток, которая вызывает анафилаксию, блокируется ингибиторами, вырабатываемыми эозинофилами.
Функции, выполняемые эозинофильными гранулоцитами, могут иметь побочные эффекты. Их активность может приводить к тромбоэмболическим повреждениям и некрозу тканей, а также вызывать обратимые изменения проницаемости стенок сосудов. Продукты секреции этих клеток могут разрушать бронхиальный эпителий и влиять на свертываемость крови, воздействуя на гепарин.

Причины и лечение
Снижение уровня эозинофилов в крови может быть вызвано как естественными, так и патологическими факторами. Эозинопенией называют состояние, при котором количество этих клеток опускается ниже 200 единиц на микролитр, а в некоторых случаях анализ может даже показать отсутствие эозинофилов. К естественным причинам этого явления относятся:
- Интенсивные физические нагрузки, которые приводят к общему истощению организма, вызывая при этом увеличение выработки других лейкоцитов и снижение числа эозинофилов.
- Хронический недосып и стрессовые ситуации, которые способствуют повышению уровня кортикостероидов, мешающих нормальному производству клеток крови костным мозгом.
- Период беременности и родов, когда эозинофилы практически не обнаруживаются в периферической крови.
Снижение уровня этих защитных клеток наблюдается практически у всех женщин в период беременности и продолжается на протяжении всего срока вынашивания. Во время родов организм испытывает сильный стресс из-за болевых ощущений, что приводит к падению числа эозинофилов до нуля. Это состояние называется абсолютной эозинопенией и может сохраняться около двух недель, после чего уровень эозинофилов постепенно восстанавливается.
Важно отметить, что эозинопения встречается реже, чем эозинофилия. Если уровень эозинофилов в крови снижен временно, это, как правило, не указывает на наличие какого-либо острого заболевания.
Патологические факторы
Системы, в которых наблюдается высокая концентрация эозинофилов, находятся в постоянном взаимодействии с окружающей средой и подвергаются воздействию чуждых частиц, проникающих в организм через воздух, пищу или воду. Низкий уровень эозинофилов может свидетельствовать о наличии определенных нарушений в организме, которые можно классифицировать следующим образом:
- Угнетение функций костного мозга.
- Инфекционные и паразитарные заболевания различной природы.
- Повышенная активность надпочечников.
Замедление процессов, ответственных за выработку лейкоцитов в костном мозге, чаще всего связано с воздействием токсинов. Это могут быть мощные медикаменты, такие как антибиотики в больших дозах, а также химиотерапевтические и противоопухолевые средства. Костное вещество может подвергаться угнетению под воздействием тяжелых металлов, углекислого газа и других химических веществ. Длительное влияние негативных факторов может привести к абсолютной эозинопении.
При наличии воспалительных процессов различной природы в организме наблюдается не столько снижение количества эозинофилов, сколько уменьшение их общей концентрации на фоне резкого увеличения числа нейтрофилов, базофилов, моноцитов и лимфоцитов. Это состояние называется относительной эозинопенией. Подобная картина может возникать после хирургических операций или в шоковых состояниях, вызванных токсинами. Некоторые заболевания, при которых отмечается снижение уровня эозинофилов:
- Дифтерия, брюшной тиф, дизентерия, пневмония и другие инфекции, вызванные бактериями, грибковыми спорами и вирусами.
- Сепсис, перитонит, острый аппендицит.
- Порфирия, диабетическая кома, острый гемолиз.
- Обширные травмы, переломы и ожоги.
- Злокачественные опухоли.
- Болевой синдром, сопровождающийся схваткообразными болями и/или судорогами.
При синдроме гиперкортицизма наблюдается повышенная функция надпочечников с увеличенной выработкой их гормонов — кортикостероидов, которые подавляют процессы кроветворения и блокируют созревание лейкоцитов, а также их выход из костного мозга. Аналогичное воздействие на продукцию эозинофилов оказывает длительный прием гормональных препаратов, таких как преднизолон и кортизон.

Особенности эозинопении у взрослых и детей
Снижение уровня эозинофильных лейкоцитов у взрослых чаще всего наблюдается в остром периоде инфекционных заболеваний и указывает на ослабление защитных функций иммунной системы или подавление кроветворения. Это свидетельствует о том, что организм не в состоянии эффективно реагировать на присутствие чуждых белков и другие неблагоприятные факторы. Для определения точной причины такого состояния могут быть назначены дополнительные анализы мочи, обследования на маркеры гепатита и анализы на гормоны щитовидной железы.
При необходимости также проводят биохимические исследования или бактериологические посевы. Одновременное снижение уровня эозинофилов и лимфоцитов требует проведения диагностических исследований, направленных на оценку функциональности костного мозга. Кратковременная эозинопения, как правило, не требует лечения, в то время как в других случаях, после проведения необходимых анализов и установления диагноза, назначается стандартная терапия.
У детей чаще фиксируется повышенное количество лейкоцитов в крови, однако также могут встречаться случаи эозинопении. Снижение уровня эозинофилов может наблюдаться как у здоровых детей, так и при различных патологических состояниях, таких как:
- аллергические реакции — крапивница, отек Квинке;
- кожные заболевания — атопический дерматит;
- гельминтозы — инвазии лямблий, аскарид, эхинококков.
Эозинопения часто встречается в анамнезе детей с синдромом Дауна и недоношенных новорожденных, перенесших сепсис. Родителям следует обратиться к врачу, если снижение показателей сохраняется длительное время. Если же это состояние связано с перенесенной инфекцией, то при адекватном лечении иммунитет восстанавливается достаточно быстро. Для общего укрепления иммунной системы и профилактики состояний, приводящих к эозинопении, специалисты рекомендуют вести здоровый образ жизни и регулярно проходить плановые медицинские обследования.
Влияние стресса и гормонов
Стресс является одним из факторов, способствующих снижению уровня эозинофилов в крови. В условиях стресса организм активирует симпатическую нервную систему, что приводит к выбросу адреналина и других стрессовых гормонов, таких как кортизол. Эти гормоны играют ключевую роль в реакции «бей или беги», подготавливая организм к быстрой реакции на угрозу.
Кортизол, в частности, обладает иммуносупрессивными свойствами. Он может подавлять активность различных клеток иммунной системы, включая эозинофилы. При повышенном уровне кортизола происходит уменьшение продукции эозинофилов в костном мозге и их высвобождения в кровоток. Это может привести к снижению их концентрации в периферической крови.
Кроме того, хронический стресс может вызывать изменения в регуляции иммунного ответа. Длительное воздействие стресса может привести к состояниям, при которых организм становится менее чувствительным к аллергенам и инфекциям, что также может способствовать снижению уровня эозинофилов. Эозинофилы, как правило, активируются в ответ на аллергены и паразитарные инфекции, и их снижение может указывать на то, что организм не реагирует должным образом на эти угрозы.
Также стоит отметить, что стресс может влиять на уровень других гормонов, таких как адренокортикотропный гормон (АКТГ), который регулирует выработку кортизола. Изменения в балансе этих гормонов могут дополнительно усугубить снижение уровня эозинофилов. Например, при повышенном уровне АКТГ может наблюдаться гиперкортицизм, что также приводит к снижению эозинофилов.
Таким образом, влияние стресса и гормонов на уровень эозинофилов в крови является сложным и многогранным процессом. Понимание этих механизмов может помочь в диагностике и лечении состояний, связанных с изменениями в уровне эозинофилов, а также в разработке стратегий по управлению стрессом для поддержания нормального функционирования иммунной системы.
Роль инфекционных заболеваний
Инфекционные заболевания могут оказывать значительное влияние на уровень эозинофилов в крови. Эозинофилы — это тип белых кровяных клеток, которые играют важную роль в иммунной системе, особенно в ответ на аллергические реакции и паразитарные инфекции. Однако в некоторых случаях, особенно при острых инфекциях, уровень эозинофилов может снижаться.
Одной из причин понижения эозинофилов является активация других компонентов иммунной системы в ответ на инфекцию. При бактериальных и вирусных инфекциях, например, происходит увеличение количества нейтрофилов и лимфоцитов, которые более активно участвуют в борьбе с патогенами. Это может привести к временной редукции эозинофилов, так как организм перераспределяет ресурсы для более эффективного реагирования на угрозу.
Кроме того, некоторые инфекционные заболевания, такие как грипп, могут вызывать системные воспалительные реакции, что также может привести к снижению уровня эозинофилов. Воспалительные медиаторы, такие как интерлейкины и факторы некроза опухолей, могут подавлять продукцию эозинофилов в костном мозге, что приводит к их уменьшению в периферической крови.
Паразитарные инфекции, хотя и могут вызывать увеличение эозинофилов, в некоторых случаях также могут приводить к их снижению. Например, при тяжелых инфекциях, таких как лейшманиоз или трипаносомоз, эозинофилы могут истощаться из-за их активного участия в борьбе с паразитами, что также может привести к их снижению в крови.
Важно отметить, что уровень эозинофилов может варьироваться в зависимости от стадии заболевания. В начальных стадиях инфекционного процесса уровень эозинофилов может быть нормальным или даже повышенным, но по мере прогрессирования заболевания и активации других клеток иммунной системы их количество может снижаться.
Таким образом, инфекционные заболевания могут оказывать как прямое, так и косвенное влияние на уровень эозинофилов в крови. Пониженные эозинофилы могут служить индикатором активного инфекционного процесса и требуют дальнейшего обследования для выявления причины изменения уровня этих клеток.
Диагностика и анализы для определения причин
Для определения причин пониженного уровня эозинофилов в крови, или эозинофилопении, необходимо провести комплексное обследование, включающее как лабораторные анализы, так и клинические исследования. Эозинофилы — это тип белых кровяных клеток, которые играют важную роль в иммунной системе, особенно в борьбе с аллергическими реакциями и паразитарными инфекциями. Их уровень может варьироваться в зависимости от различных факторов, и для точной диагностики важно учитывать множество аспектов.
Первым шагом в диагностике является общий анализ крови, который позволяет определить количество эозинофилов и выявить возможные отклонения от нормы. Нормальный уровень эозинофилов составляет от 0 до 0,5 × 109/л. Если результаты анализа показывают пониженное количество этих клеток, врач может назначить дополнительные исследования для выяснения причин.
Одним из ключевых анализов является биохимический анализ крови, который помогает оценить функцию печени и почек, а также уровень электролитов. Патологии этих органов могут влиять на уровень эозинофилов. Например, заболевания печени могут приводить к изменению метаболизма и снижению продукции эозинофилов.
Также важно учитывать наличие хронических заболеваний, таких как диабет, заболевания щитовидной железы или аутоиммунные расстройства. В таких случаях может потребоваться более углубленное обследование, включая анализы на гормоны, антитела и другие специфические маркеры.
Кроме того, врач может назначить аллергологические тесты, чтобы исключить или подтвердить наличие аллергий, которые могут влиять на уровень эозинофилов. Важно помнить, что эозинофилы часто повышаются при аллергических реакциях, но их уровень может снижаться при хронических аллергиях, когда организм адаптируется к аллергену.
Если есть подозрение на инфекцию, особенно паразитарную, могут быть назначены специфические тесты для выявления возбудителей. Например, анализы на наличие гельминтов или других паразитов могут помочь установить причину снижения уровня эозинофилов.
Не менее важным аспектом является сбор анамнеза. Врач должен узнать о наличии симптомов, таких как потеря веса, усталость, изменения в аппетите или другие проявления, которые могут указать на основное заболевание. Также следует учитывать факторы образа жизни, такие как стресс, диета и прием медикаментов, которые могут влиять на уровень эозинофилов.
В заключение, диагностика причин пониженных эозинофилов в крови требует комплексного подхода, включающего лабораторные анализы, клинические исследования и сбор анамнеза. Только после тщательного обследования можно установить точную причину и назначить соответствующее лечение.